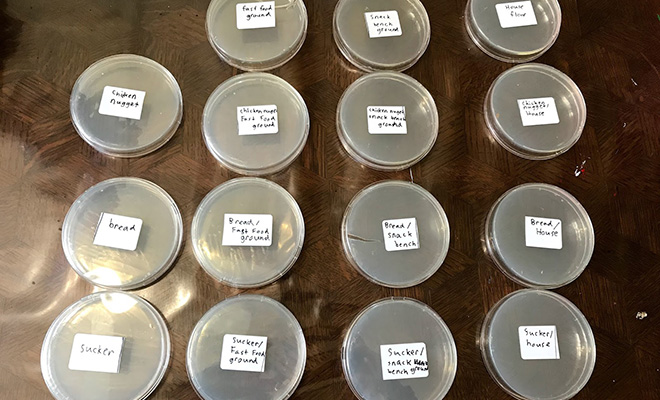
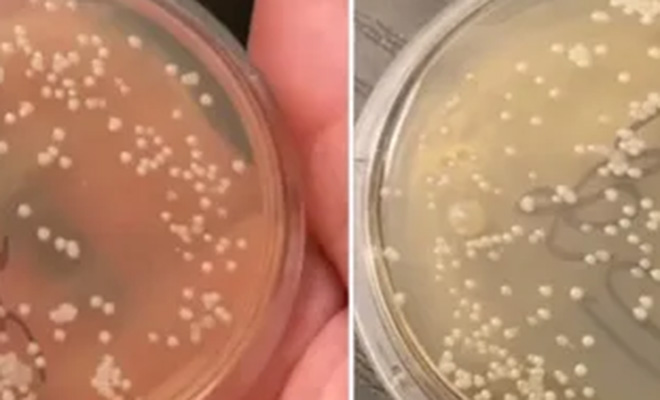

Быстро поднятая еда не считается упавшей. Так ли это, проверил микробиолог
Микробиолог Николас Айхер решил проверить распространенный миф о правиле 5 секунд — во многих странах мира люди считают, что упавшая на землю еда, если ее быстро поднять, «упавшей не считается». С помощью нехитрых инструментов и чашки Петри ученый провел эксперимент и показал, что происходит с едой даже за 1 секунду.

В ходе эксперимента Айхер разложил чашки Петри на полу, фиксируя количество бактерий, осевших на поверхность за 0, 5, 10, 30 и 60 секунд. Даже нулевая экспозиция — когда чашка просто коснулась пола — показала активный рост микробов. А образцы, пролежавшие дольше, «цвели» бактериями также сильно. Результаты ясно говорят: упало — стало грязным, независимо от времени.
«Похоже, даже ноль секунд — уже слишком много», — резюмировал ученый, показывая чашку, покрытую белыми бактериальными колониями. Эксперимент вызвал бурю обсуждений в TikTok: клип с анализом собрал свыше миллиона просмотров, а подписчиков у Айхера — уже почти полмиллиона.
Показательно, что и пятиминутный, и минутный образцы выглядели практически одинаково. Это говорит о том, что передача бактерий происходит мгновенно, а не со временем. Всё, что лежит на полу — уже заражено. И да, никакой «зоны безопасности» не существует.
С научной точки зрения всё логично: на поверхностях всегда есть микрофлора — даже на чисто вымытом полу. При падении пища моментально контактирует с колониями микроорганизмов, а значит, становится потенциально опасной для употребления.

